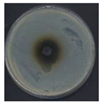
Molecules 27 00487 i002

Bioactive Properties of a Novel Antibacterial Dye Obtained from Laccase-Mediated Oxidation of 8-Anilino-1-naphthalenesulfonic Acid
Abstract
1. Introduction
2. Results and Discussion
2.1. Laccase-Mediated Transformation of 8-Anilinonaphthalenesulfonic Acid
2.2. Properties of the Dye
3. Materials and Methods
3.1. Chemicals
3.2. Preparations of Purified Laccase
3.3. Substrate Characterisation
3.4. Laccase-Mediated Transformation of Substrate ANS—Optimisation Process
3.5. Large-Scale Synthesis of the Dye
3.6. Characterisation of the Dye
3.7. Properties of Dye
3.7.1. Toxicity
Environmental Toxicity
Cytotoxicity
3.7.2. Antimicrobial Properties
3.7.3. Antioxidant Properties
3.7.4. Dyeing Properties
3.7.5. Allergenicity—Patch Test
4. Conclusions
Author Contributions
Funding
Institutional Review Board Statement
Informed Consent Statement
Acknowledgments
Conflicts of Interest
Sample Availability
References
- Pezzella, C.; Guarino, L.; Piscitelli, A. How to enjoy laccases. Cell Mol. Life Sci. 2015, 72, 923–940. [Google Scholar] [CrossRef]
- Widsten, P.; Kandelbauer, A. Laccase applications in the forest products industry: A review. Enzym. Microb. Technol. 2008, 42, 293–307. [Google Scholar] [CrossRef]
- Mate, D.M.; Alcade, M. Laccase: A multi-purpose biocatalyst at the forefront of biotechnology. Microb. Biotechnol. 2017, 10, 1457–1467. [Google Scholar] [CrossRef]
- Pozdnyakova, N.; Jarosz-Wilkolazka, A.; Polak, J.; Wlizlo, K.; Dubrovskaya, E.; Turkovskaya, O. Unique properties of fungal laccases for biodegradative processes. In Laccase: Applications, Investigations and Insights; Harris, A., Ed.; Nova Science Publishers: Hauppauge, NY, USA, 2017. [Google Scholar]
- Mayolo-Deloisa, K.; González-González, M.; Rito-Palomares, M. Laccases in food industry: Bioprocessing, potential industrial and biotechnological applications. Front. Bioeng. Biotechnol. 2020, 8, 222. [Google Scholar] [CrossRef]
- Mikolasch, A.; Manda, K.; Schlüter, R.; Lalk, M.; Witt, S.; Seefeldt, S.; Hammer, E.; Schauer, F.; Jülich, W.D.; Lindequist, U. Comparative analyses of laccase-catalyzed amination reactions for production of novel β-lactam antibiotics. Biotechnol. Appl. Biochem. 2012, 59, 295–306. [Google Scholar] [CrossRef] [PubMed]
- Pezzela, C.; Giacobbe, S.; Giacobelli, V.G.; Guarino, L.; Kylic, S.; Sener, M.; Sannia, G.; Piscitelli, A. Green routes towards industrial textile dyeing: A laccase based approach. J. Mol. Catal. B Enzym. 2016, 134, 274–279. [Google Scholar] [CrossRef]
- Kudanga, T.; Nemadziva, B.; Le Roes-Hill, M. Laccase catalysis for the synthesis of bioactive compounds. Appl. Microbiol. Biotechnol. 2017, 101, 13–33. [Google Scholar] [CrossRef]
- Bassanini, I.; Ferrandi, E.E.; Riva, S.; Monti, D. Biocatalysis with laccases: An updated overview. Catalysts 2021, 11, 26. [Google Scholar] [CrossRef]
- Sousa, A.C.; Martins, L.O.; Robalo, M.P. Laccases: Versatile biocatalysts for the synthesis of heterocyclic cores. Molecules 2021, 26, 3719. [Google Scholar] [CrossRef] [PubMed]
- Adelakun, O.E.; Kudanga, T.; Parker, A.; Green, I.R.; le Roes-Hill, M.; Burton, S.G. Laccase catalyzed dimerization of ferulic acid amplifies antioxidant activity. J. Mol. Catal. B Enzym. 2012, 74, 29–35. [Google Scholar] [CrossRef]
- Rocasalbas, G.; Francesko, A.; Touriño, S.; Fernández-Francos, X.; Guebitz, G.M.; Tzanov, T. Laccase-assisted formation of bioactive chitosan/gelatin hydrogel stabilized with plant polyphenols. Carbohydr. Polym. 2013, 92, 989–996. [Google Scholar] [CrossRef] [PubMed]
- Sousa, A.C.; Conceição Oliveira, M.; Martins, L.O.; Robalo, M.P. Towards the rational biosynthesis of substituted phenazines and phenoxazinones by laccases. Green Chem. 2014, 16, 4019–4030. [Google Scholar] [CrossRef]
- Sousa, A.C.; Piedade, M.F.M.; Martins, L.O.; Robalo, M.P. Eco-friendly synthesis of indo dyes mediated by a bacterial laccase. Green Chem. 2016, 18, 6063. [Google Scholar] [CrossRef][Green Version]
- Polak, J.; Wlizło, K.; Pogni, R.; Petricci, E.; Grąz, M.; Szałapata, K. Structure and bioactive properties of novel textile dyes synthesised by fungal laccase. Int. J. Mol. Sci. 2020, 21, 2052. [Google Scholar] [CrossRef] [PubMed]
- Forte, S.; Polak, J.; Valensin, D.; Taddei, M.; Basosi, R.; Vanhulle, S.; Jarosz-Wilkołazka, A.; Pogni, R. Synthesis and structural characterization of a novel phenoxazinone dye by use of a fungal laccase. J. Mol. Catal. B Enzym. 2010, 63, 116–120. [Google Scholar] [CrossRef]
- Polak, J.; Jarosz-Wilkołazka, A.; Szałapata, K.; Grąz, M.; Osińska-Jaroszuk, M. Laccase-mediated synthesis of a phenoxazine compound with antioxidative and dyeing properties–the optimisation process. New Biotechnol. 2016, 33, 255–262. [Google Scholar] [CrossRef] [PubMed]
- Sousa, A.C.; Oliveira, M.C.; Martins, L.O.; Robalo, M.P. A sustainable synthesis of asymmetric phenazines and phenoxazinones mediated by CotA-laccase. Adv. Synth. Catal. 2018, 360, 575–583. [Google Scholar] [CrossRef]
- Enaud, E.; Trovaslet, M.; Bruyneel, F.; Billottet, L.; Karaaslan, R.; Sener, M.E.; Coppens, P.; Casas, A.; Jaeger, I.J.; Hafner, C.; et al. A novel azoanthraquinone dye made through innovative enzymatic process. Dyes Pigment. 2010, 85, 99–108. [Google Scholar] [CrossRef]
- Robinson, G.W.; Robbins, R.J.; Fleming, G.R.; Morris, J.M.; Knight, A.E.W.; Morrison, R.J.S. Picosecond studies of the fluorescence probe molecule 8-anilino-1-naphthalenesulfonic acid. J. Am. Chem. Soc. 1978, 100, 7145–7150. [Google Scholar] [CrossRef]
- Gasymov, O.K.; Abduragimov, A.R.; Glasgow, B.J. Ligand binding site of tear lipocalin: Contribution of a trigonal cluster of charged residues probed by 8-anilino-1-naphthalenesulfonic acid. Biochemistry 2008, 47, 1414–1424. [Google Scholar] [CrossRef] [PubMed]
- Singh, K.; Hussain, I.; Mishra, V.; Md Akhtar, S. New insight on 8-anilino-1-naphthalene sulfonic acid interaction with TgFNR for hydrophobic exposure analysis. Int. J. Biol. Macromol. 2019, 122, 636–643. [Google Scholar] [CrossRef] [PubMed]
- Ota, C.; Tanaka, S.-I.; Takano, K. Revisiting the rate-limiting step of the ANS–protein binding at the protein surface and inside the hydrophobic cavity. Molecules 2021, 26, 420. [Google Scholar] [CrossRef]
- Wu, F.; Hu, Z.; Zhang, Y.; Cheng, L. Preparation Method of N-Phenyl-8-Naphthylamine-1-Sulfonic Acid. CN Patent 105,439,912, 30 March 2016. [Google Scholar]
- Wang, N.; Faber, E.B.; Georg, G.I. Synthesis and spectral properties of 8-anilinonaphthalene-1-sulfonic acid (ANS) derivatives prepared by microwave-assisted copper(0)-catalyzed Ullmann reaction. ACS Omega 2019, 4, 18472–18477. [Google Scholar] [CrossRef]
- Nachiyar, C.V.; Rajakumar, G.S. Biodegradation of 8-anilino-1-naphthalenesulfonic acid by Pseudomonas aeruginosa. J. Ind. Microbiol. Biotechnol. 2006, 33, 845–849. [Google Scholar] [CrossRef] [PubMed]
- Moreno, A.D.; Ibarra, D.; Eugenio, M.E.; Tomás-Pejóc, E. Laccases as versatile enzymes: From industrial uses to novel applications. Chem. Technol. Biotechnol. 2020, 95, 481–494. [Google Scholar] [CrossRef]
- Janusz, G.; Pawlik, A.; Świderska-Burek, U.; Polak, J.; Sulej, J.; Jarosz-Wilkołazka, A.; Paszczyński, A. Laccase properties, physiological functions, and evolution. Int. J. Mol. Sci. 2020, 21, 966. [Google Scholar] [CrossRef] [PubMed]
- Polak, J.; Jarosz-Wilkołazka, A. Structure/redox potential relationship of simple organic compounds as potential precursors of dyes for laccase-mediated transformation. Biotechnol. Prog. 2012, 23, 93–102. [Google Scholar] [CrossRef]
- Xu, F. Effects of redox potential and hydroxide inhibition on the pH activity profile of fungal laccases. J. Biol. Chem. 1997, 272, 924–928. [Google Scholar] [CrossRef]
- Wlizło, K.; Polak, J.; Jarosz-Wilkołazka, A.; Pogni, R.; Petricci, E. Novel textile dye obtained through transformation of 2-amino-3-methoxybenzoic acid by free and immobilised laccase from a Pleurotus ostreatus strain. Enzym. Microb. Technol. 2020, 132, 109398. [Google Scholar] [CrossRef]
- Brown, M.A.; De Vito, S.C. Predicting azo dye toxicity. Crit. Rev. Environ. Sci. Technol. 1993, 23, 249–324. [Google Scholar] [CrossRef]
- Patel, H.; Gupte, A. Laccase catalysis: A green approach in bioactive compound synthesis. In Research Advancements in Pharmaceutical, Nutritional, and Industrial Enzymology; IGI Global Publisher: Pennsylvania, PA, USA, 2019. [Google Scholar] [CrossRef]
- Mikolasch, A.; Wurster, M.; Lalk, M.; Witt, S.; Seefeldt, S.; Hammer, E.; Schauer, F.; Jülich, W.D.; Lindequist, U. Novel beta-lactam antibiotics synthesized by amination of catechols using fungal laccase. Chem. Pharm. Bull. 2008, 56, 902–907. [Google Scholar] [CrossRef] [PubMed][Green Version]
- Mikolasch, A.; Hildebrandt, O.; Schlüter, R.; Hammer, E.; Witt, S.; Lindequist, U. Targeted synthesis of novel β-lactam antibiotics by laccase-catalyzed reaction of aromatic substrates selected by pre-testing for their antimicrobial and cytotoxic activity. Appl. Microbiol. Biotechnol. 2016, 100, 4885–4899. [Google Scholar] [CrossRef] [PubMed]
- Santos-Sánchez, N.F.; Salas-Coronado, R.; Villanueva-Cañongo, C.; Hernández-Carlos, B. Antioxidant compounds and their antioxidant mechanism. In Antioxidants; IntechOpen: London, UK, 2019. [Google Scholar] [CrossRef]
- Burton, S.G.; Davids, L.M. Hydroxytyrosol Compounds. U.S. Patent No. 8,663,608, 14 March 2014. [Google Scholar]
- Luterek, J.; Gianfreda, L.; Wojtaś-Wasilewska, M.; Rogalski, J.; Jaszek, M.; Malarczyk, E.; Dawidowicz, A.; Ginalska, G.; Leonowicz, A.; Finks-Boots, M. Screening of the wood rotting fungi for laccase production: Induction by ferulic acid, partial purification, and immobilization of laccase from the high laccase-producing strain, Cerrena unicolor. Acta Microbiol. Pol. 1997, 46, 297–311. [Google Scholar]
- Bernhardt, F.-H.; Staudinger, H.; Ulrich, V. The properties of p-anisate O-demethylase in cell-free extracts of Pseudomonas sp. Hoppe-Seyler’s Z. Physiol. Chem. 1970, 351, 467–478. [Google Scholar] [CrossRef]
- CLSI Method for dilution antimicrobial susceptibility testing for bacteria that grow aerobically. In Approved Standard, 9th ed.; (M07-A9); Clinical & Laboratory Standards Institute (Former NCCLS): Wayne, PA, USA, 2012.
- Product Test Guidelines for the Assessment of Human Skin Compatibility. 1997. Available online: https://www.cosmeticseurope.eu/files/6014/6407/8875/Product_Test_Guidelines_for_the_Assessment_of_Human_Skin_Compatibility_-_1997.pdf (accessed on 18 May 2020).
- Guidelines for the Evaluation of the Efficacy of Cosmetic Products. 2008. Available online: https://cosmeticseurope.eu/files/4214/6407/6830/Guidelines_for_the_Evaluation_of_the_Efficacy_of_Cosmetic_Products_-_2008.pdf (accessed on 18 May 2020).




| Chemical Structure | Oxygen Demand (nM/min/mL) | Eo vs. NHE (V) | Optimal pH | KM (mM) | λ max1 (nm) | λ max2 (nm) |
|---|---|---|---|---|---|---|
 | 1583 | 0.768 | 4 | 0.435 | 340–350 | 420–440 |
| Tested Compounds | EC50 (mg/mL) |
|---|---|
| ANS | 0.019 |
| Dye | 0.067 |
| Tested Compounds | Colon Epithelial Cells | Fibroblasts | ||
|---|---|---|---|---|
| LDH | MTT | LDH | MTT | |
| ANS | 0.382 | 0.322 | 0.247 | 0.295 |
| Dye | 0.436 | 0.473 | 0.321 | 0.363 |
| Tested Compounds | S. aureus (0.51 × 102 cfu/mL) | S. epidermidis (0.05 × 102 cfu/mL) | Inhibition Zone Caused by Dye (S. aureus) | ||
|---|---|---|---|---|---|
| MIC | MBC | MIC | MBC | ||
| ANS | 0.2 | 0.4 | 0.025 | 0.4 | |
| Dye | 0.4 | 1.0 | 0.025 | 0.1 | |
| Tested Compounds | Method | ||
|---|---|---|---|
| ABTS | DPPH | Luminol | |
| ANS | 0.027 | 153 | 6 |
| Dye | 0.115 | 660 | 42 |
| Tested Parameters of Colour Fastness (ISO Standard) | Scale * | |
|---|---|---|
| Artificial light (1) (PN-EN ISO 105-B02:2014-11) | (a) | 6–7 |
| Distilled water (2) (PN-EN ISO 105-E01:2013-06) | (a) | 4 |
| (b) | 4–5 | |
| (c) | 4 | |
| Washing 40 °C (2) (PN-EN ISO 105-C06:2010) | (a) | 2 |
| (b) | 4–5 | |
| (c) | 4–5 | |
| Alkaline sweat (2) (PN-EN ISO 105-E04:2013-06) | (a) | 4–5 |
| (b) | 3–4 | |
| (c) | 3 | |
| Acidic sweat (2) (PN-EN ISO 105-E01:2013-06) | (a) | 4–5 |
| (b) | 4–5 | |
| (c) | 4 | |
| Dry rubbing (2) (PN-EN ISO 105-X12:2005) | (b) | 3 |
| Wet rubbing (2) (PN-EN ISO 105-X12:2005) | (b) | 3–4 |
| Probant No. | 1 | 2 | 3 | 4 | 5 | 6 | 7 | 8 | 9 | 10 | 11 | 12 | 13 | 14 | 15 | 16 | 17 | 18 | 19 | 20 | 21 | 22 | 23 | 24 | 25 | 26 | 27 | 28 | 29 | 30 | 31 | 32 | 33 | 34 | 35 | 36 | 37 | 38 | 39 | 40 | 41 | 42 | 43 | 44 | 45 | 46 | 47 | 48 | 49 | 50 | |
|---|---|---|---|---|---|---|---|---|---|---|---|---|---|---|---|---|---|---|---|---|---|---|---|---|---|---|---|---|---|---|---|---|---|---|---|---|---|---|---|---|---|---|---|---|---|---|---|---|---|---|---|
| Sex (1) | M | F | F | F | F | F | F | F | F | M | M | F | F | F | F | F | M | F | F | F | M | M | M | F | M | M | F | M | F | M | F | M | M | M | M | F | F | F | F | F | F | F | F | F | F | M | F | F | F | F | |
| Age | 33 | 28 | 50 | 54 | 42 | 39 | 26 | 70 | 49 | 51 | 70 | 33 | 19 | 53 | 22 | 22 | 30 | 23 | 50 | 70 | 40 | 69 | 23 | 70 | 36 | 65 | 70 | 40 | 37 | 40 | 20 | 67 | 38 | 69 | 66 | 33 | 65 | 35 | 40 | 31 | 40 | 41 | 24 | 24 | 35 | 27 | 54 | 31 | 31 | 29 | |
| Skin type (2) | S | S | S | SA | S | S | S | S | S | SA | S | S | S | S | S | S | SA | S | S | S | S | S | S | S | S | S | S | S | S | S | S | S | S | S | S | S | S | S | S | S | S | S | S | S | S | S | S | SA | SA | S | |
| Skin response (3) | 48 h | - | - | - | - | - | - | - | - | - | - | - | - | - | - | - | - | - | - | - | - | - | - | - | - | - | - | - | - | - | - | - | - | - | - | - | - | - | - | - | - | - | - | - | - | - | - | - | - | - | |
| 72 h | - | - | - | - | - | - | - | - | - | - | - | - | - | - | - | - | - | - | - | - | - | - | - | - | - | - | - | - | - | - | - | - | - | - | - | - | - | - | - | - | - | - | - | - | - | - | - | - | - | ||
Publisher’s Note: MDPI stays neutral with regard to jurisdictional claims in published maps and institutional affiliations. |
© 2022 by the authors. Licensee MDPI, Basel, Switzerland. This article is an open access article distributed under the terms and conditions of the Creative Commons Attribution (CC BY) license (https://creativecommons.org/licenses/by/4.0/).
Share and Cite
Polak, J.; Grąz, M.; Wlizło, K.; Szałapata, K.; Kapral-Piotrowska, J.; Paduch, R.; Jarosz-Wilkołazka, A. Bioactive Properties of a Novel Antibacterial Dye Obtained from Laccase-Mediated Oxidation of 8-Anilino-1-naphthalenesulfonic Acid. Molecules 2022, 27, 487. https://doi.org/10.3390/molecules27020487
Polak J, Grąz M, Wlizło K, Szałapata K, Kapral-Piotrowska J, Paduch R, Jarosz-Wilkołazka A. Bioactive Properties of a Novel Antibacterial Dye Obtained from Laccase-Mediated Oxidation of 8-Anilino-1-naphthalenesulfonic Acid. Molecules. 2022; 27(2):487. https://doi.org/10.3390/molecules27020487
Chicago/Turabian StylePolak, Jolanta, Marcin Grąz, Kamila Wlizło, Katarzyna Szałapata, Justyna Kapral-Piotrowska, Roman Paduch, and Anna Jarosz-Wilkołazka. 2022. "Bioactive Properties of a Novel Antibacterial Dye Obtained from Laccase-Mediated Oxidation of 8-Anilino-1-naphthalenesulfonic Acid" Molecules 27, no. 2: 487. https://doi.org/10.3390/molecules27020487
APA StylePolak, J., Grąz, M., Wlizło, K., Szałapata, K., Kapral-Piotrowska, J., Paduch, R., & Jarosz-Wilkołazka, A. (2022). Bioactive Properties of a Novel Antibacterial Dye Obtained from Laccase-Mediated Oxidation of 8-Anilino-1-naphthalenesulfonic Acid. Molecules, 27(2), 487. https://doi.org/10.3390/molecules27020487






